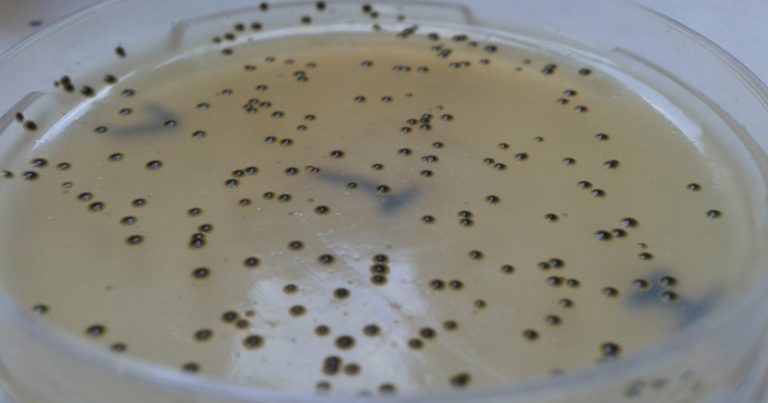
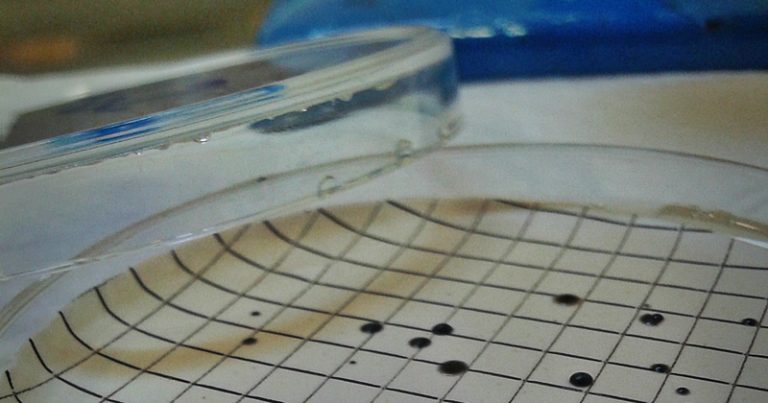

Pesquisa da Faculdade de Saúde Pública identificou a bactéria em bebedouros de parques em São Paulo, mas ainda não há indícios de que isso possa representar perigo aos usuários
A água que consumimos passa por uma série de análises, preconizadas pela legislação, que avaliam se ela está boa para o consumo humano. Entretanto, existem alguns organismos causadores de doenças, chamados de patógenos, que não são usados como parâmetro de sua qualidade. Entre eles está o Staphylococcus aureus, bactéria que compõe a pele humana e se torna perigosa em contextos de imunidade comprometida, sendo muito comum em infecções hospitalares.
Uma pesquisa realizada na Faculdade de Saúde Pública (FSP) da USP constatou a ocorrência dessa bactéria na água de bebedouros e aspersores de quatro parques públicos de São Paulo. A pesquisa foi desenvolvida pela biomédica Geyse Aparecida Cardoso Santos e orientada pela professora Maria Tereza Pepe Razzolini.
Segundo a pesquisadora, um dos principais objetivos do trabalho era saber se esse patógeno, mais comum em infecções humanas e animais, estava sobrevivendo na água. “O S. aureus possui uma habilidade de se adaptar a diversos estresses que sofre e consegue desenvolver resistência a antibióticos para infecções básicas até as mais graves”, explica.
Riscos a saúde
Não existe nenhum estudo que mostre que a ingestão de água contendo a bactéria gere infecções ou doenças em pessoas ou animais. Entretanto, Geyse aponta justamente para o fato da possibilidade de existirem riscos, e estes não serem conhecidos.
O trabalho teve apoio da Secretaria do Verde e Meio Ambiente (SVMA) da Cidade de São Paulo e autorização do Departamento de Parques e Áreas Verdes (Depave-5).
As amostras de água foram coletadas dos bebedouros e aspersores dos parques da Aclimação, Ibirapuera, Piqueri e Buenos Aires, escolhidos com base na localização, frequência de usuários e utilização dos referidos dispositivos públicos.
Inicialmente, foram coletadas 552 amostras, das quais 462 eram de água dos bebedouros e 84 de biofilme (placa de bactérias) dos aspersores. No laboratório, as amostras passaram por uma membrana filtrante que deixa passar impurezas, mas retira as bactérias. Em seguida, a membrana foi colocada em um meio de cultura seletivo para o crescimento de determinadas bactérias, nesse caso o Staphylococcus, e incubada a 36ºC por aproximadamente 24 horas. Após as bactérias crescerem, foi realizada uma contagem, para saber a quantidade que havia delas e seguiram para as análises complementares, como a que verifica a morfologia do patógeno.
De acordo com a legislação
As análises também incluíram a verificação dos parâmetros de potabilidade estabelecidos pela lei como a quantidade de cloro, bactérias heterotróficas (grupo de bactérias que compõem a água, mas que acima do limite podem demonstrar alguma contaminação) e Escherichia coli. “Na legislação, a água estava ok para o consumo. Só que cresceram bactérias do tipo Staphylococcus. Então fomos investigar se era realmente Staphylococcus aureus“, comenta Geyse.
O resultado apontou para a presença do tipo aureus da bactéria tanto nas amostras dos bebedouros quanto dos aspersores, além de outros gêneros. Foram detectados em 23 amostras dos quatro parques de São Paulo, que recebem abastecimento público. A origem da contaminação não foi descoberta durante as pesquisas.
A bactéria não só estava presente nas amostras como apresentou resistência a antibióticos, detectada a partir de testes de antibiograma. Staphylococcus resistentes a meticilina, droga amplamente usada para tratar infecções hospitalares.
Algumas amostras apresentaram resistência a meticilina e tinham o gene mecA, responsável por essa expressão. Já outras não eram resistentes, mas carregaram o gene. Geyse alerta para esses patógenos: “Essas também devem ser levadas em consideração porque as bactérias trocam genes e, em um ambiente onde sofram diversos estresses, podem desencadear uma resposta”. É um gene que está presente e pode acabar se manifestando em função das circunstâncias. Essa troca de material genético também está relacionada ao aumento da resistência a antibióticos.
O S. aureus não é utilizado como indicador bacteriológico para água em nenhum país do mundo. Mas de acordo com Geyse é necessário ter precaução para a presença da bactéria na água, já que os riscos não são conhecidos. “Não existem dados e pesquisas que discutam esse risco. O Staphylococcus não só pode expressar resistência, como pode transportar tais genes para outras bactérias, inclusive para as bactérias indicadoras de qualidade de água”, completa a pesquisadora.
Pesquisa
É preciso ter um cuidado maior com os dispositivos de uso público e os hábitos de higiene, como lavar as mãos antes de usá-los. Essas medidas já ajudam na prevenção da contaminação da água pelo S. aureus, bem como não deixar animais entrarem em contato com os dispositivos, evitar contato direto com a saída de água e não lavar objetos no bebedouro. A presença da bactéria na água não é algo comum. Nesse meio, ela tem todos os recursos nutricionais para crescer e ficar forte. “Ela pode se adaptar e se comportar totalmente diferente do que esperamos em uma infecção clínica”, explica Geyse.
Na fase atual do trabalho, a pesquisadora está estudando as outras espécies de Staphylococcus que foram encontradas nas amostras de água, qual o risco de infecção em humanos e animais, e se são resistentes a antibióticos.
Além disso, os resultados serão apresentados para a Secretaria do Verde e Meio Ambiente e discutidos, com o objetivo de pensar medidas sanitárias para prevenção da contaminação de bebedouros e aspersores.
O mestrado Ocorrência de Staphylococcus aureus em amostras de água de bebedouros e de aspersores em parques públicos da cidade de São Paulo foi defendido em março de 2019.
Fonte: Jornal da USP.